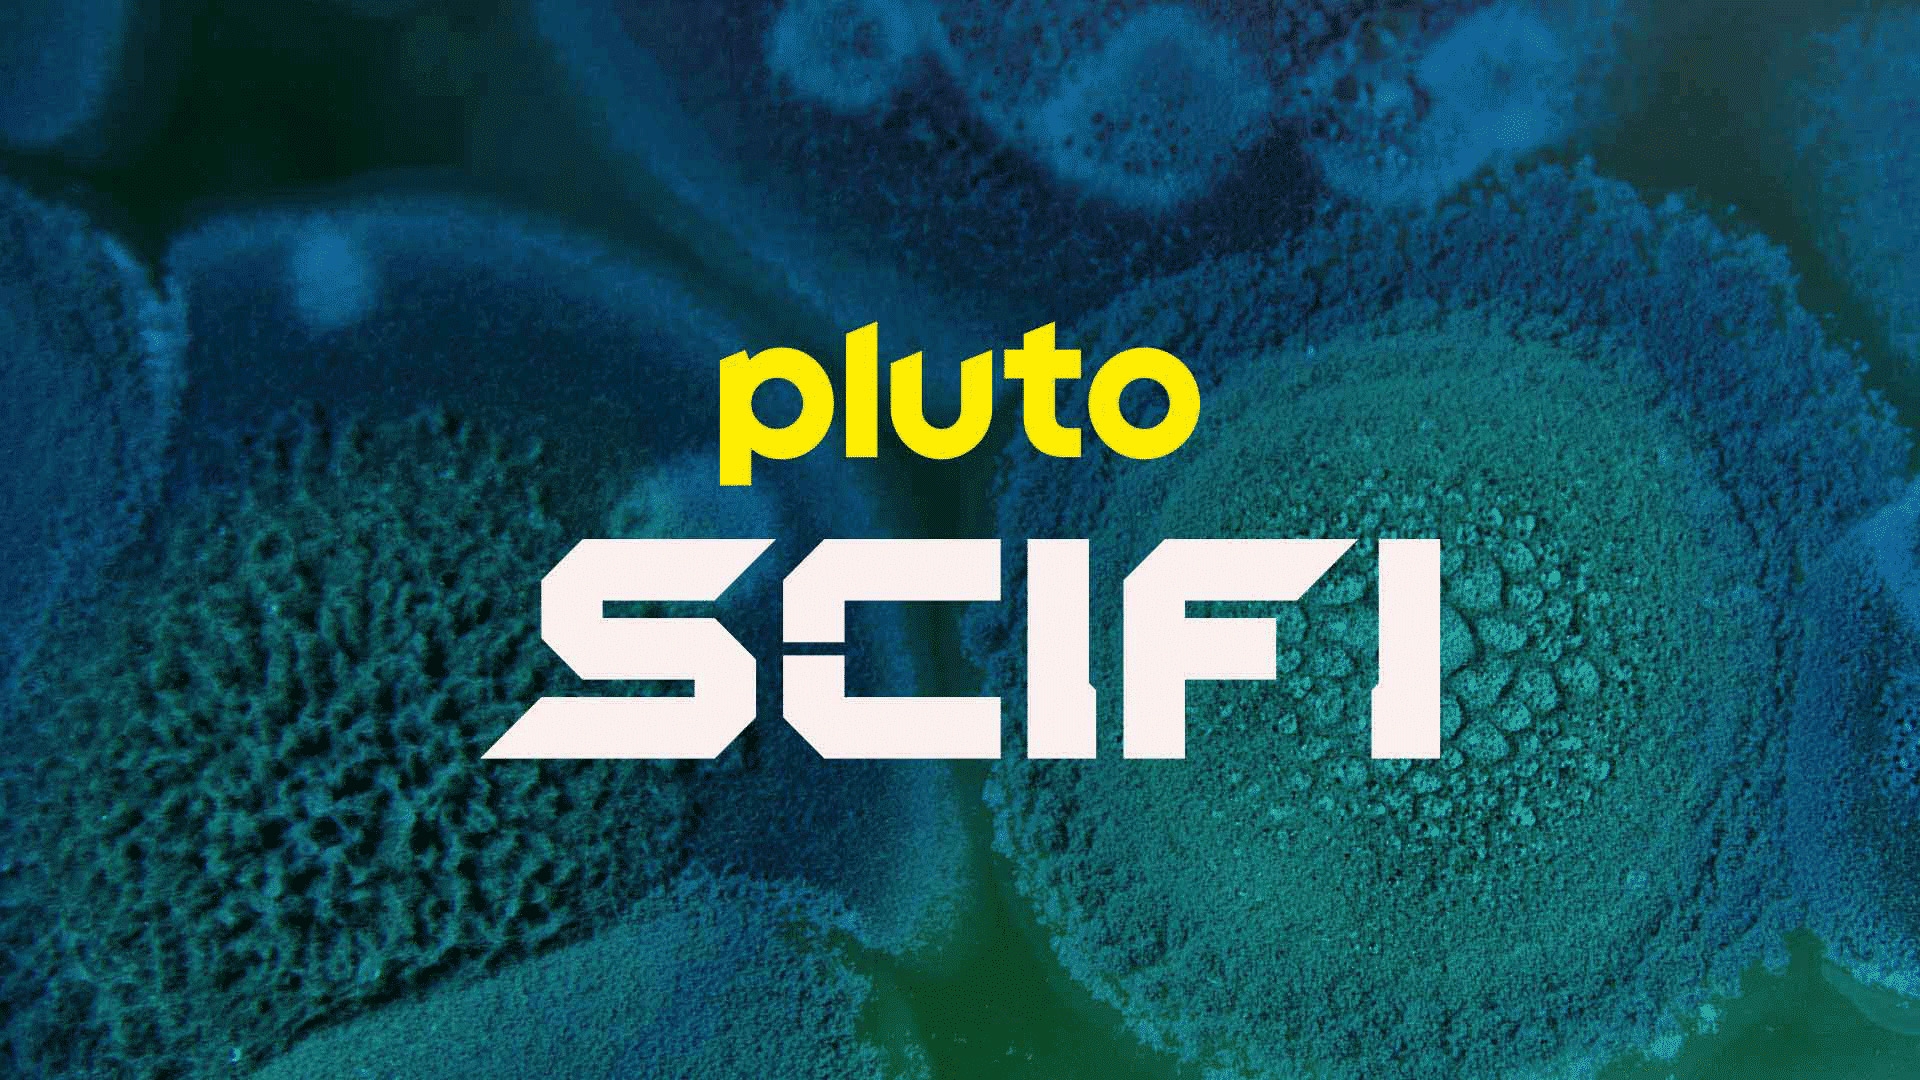
sci fi channel tv guide sci fi channel tv guide

If you’re a fan of all things sci-fi and you love watching TV shows, then you’ve come to the right place! The Sci Fi Channel has a fantastic lineup of shows that are sure to keep you entertained for hours on end.
From classic sci-fi series to new and exciting shows, the Sci Fi Channel has something for everyone. Whether you’re into aliens, time travel, or dystopian futures, you’ll find it all on this channel. Get ready to embark on a journey to other worlds and beyond!
sci fi channel tv guide
Sci Fi Channel TV Guide: What to Watch
One of the most popular shows on the Sci Fi Channel is “Stranger Things,” a thrilling series that takes place in the 1980s and follows a group of kids as they uncover supernatural mysteries in their town. If you’re a fan of nostalgia and suspense, this is the show for you!
Another must-watch show on the Sci Fi Channel is “The Expanse,” a space opera that takes place in a future where humanity has colonized the solar system. Follow the crew of the Rocinante as they navigate political intrigue, alien technology, and the mysteries of the universe.
If you’re in the mood for something a bit lighter, check out “The Orville,” a sci-fi comedy series created by Seth MacFarlane. This show follows the crew of the USS Orville as they explore the galaxy and encounter strange new worlds and civilizations. It’s a fun and quirky take on the sci-fi genre that is sure to make you laugh!
So grab your popcorn, settle in on the couch, and get ready for an out-of-this-world TV experience with the Sci Fi Channel. With its diverse lineup of shows, there’s always something new and exciting to watch. Happy viewing!

TV GUIDE Magazine June 10 16 2013 True Blood Falling Skies Sci Fi Preview EBay

The Sci Fi Channel Encyclopedia Of TV Science Fiction And Sci Fi On Tape 9780446674782 EBay

The Sci Fi Channel Encyclopedia Of TV Science Fiction By John Gregory Betancourt 9780446674782 EBay

What Was First Show On Sci Fi Channel Now SYFY